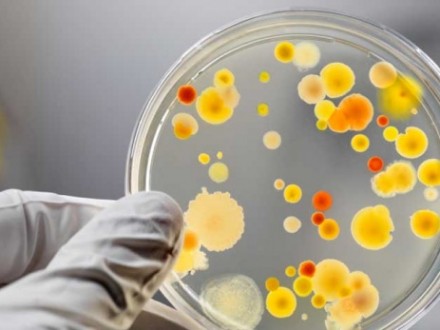
У Житомирі 13 дітей опинились в лікарні із харчовим отруєнням

Тринадцять дітей опинились на лікарняних ліжках із діагнозом “харчове отруєння” у Житомирі. Таку інформацію озвучили під час термінового брифінгу, повідомляє прес-служба міської ради, передає УНН.
Всі діти — учні місцевої гімназії, наразі їхній стан задовільний.
Всі необхідні аналізи спеціалісти відібрали, втім збудник отруєння поки не виявлено, також не виявлено сальмонельозу.
Харчування у їдальні гімназії з понеділка буде припинено до з’ясування причин отруєння.
Раніше місцеві жителі та активісти повідомляли в соціальних мережах про випадки отруєння у їхніх дітей.
Нагадаємо, 15 січня у Харкові родина отруїлася невстановленою речовиною, до лікарні доставили шістьох дорослих та 10-річну дитину.
Джерело: УНН